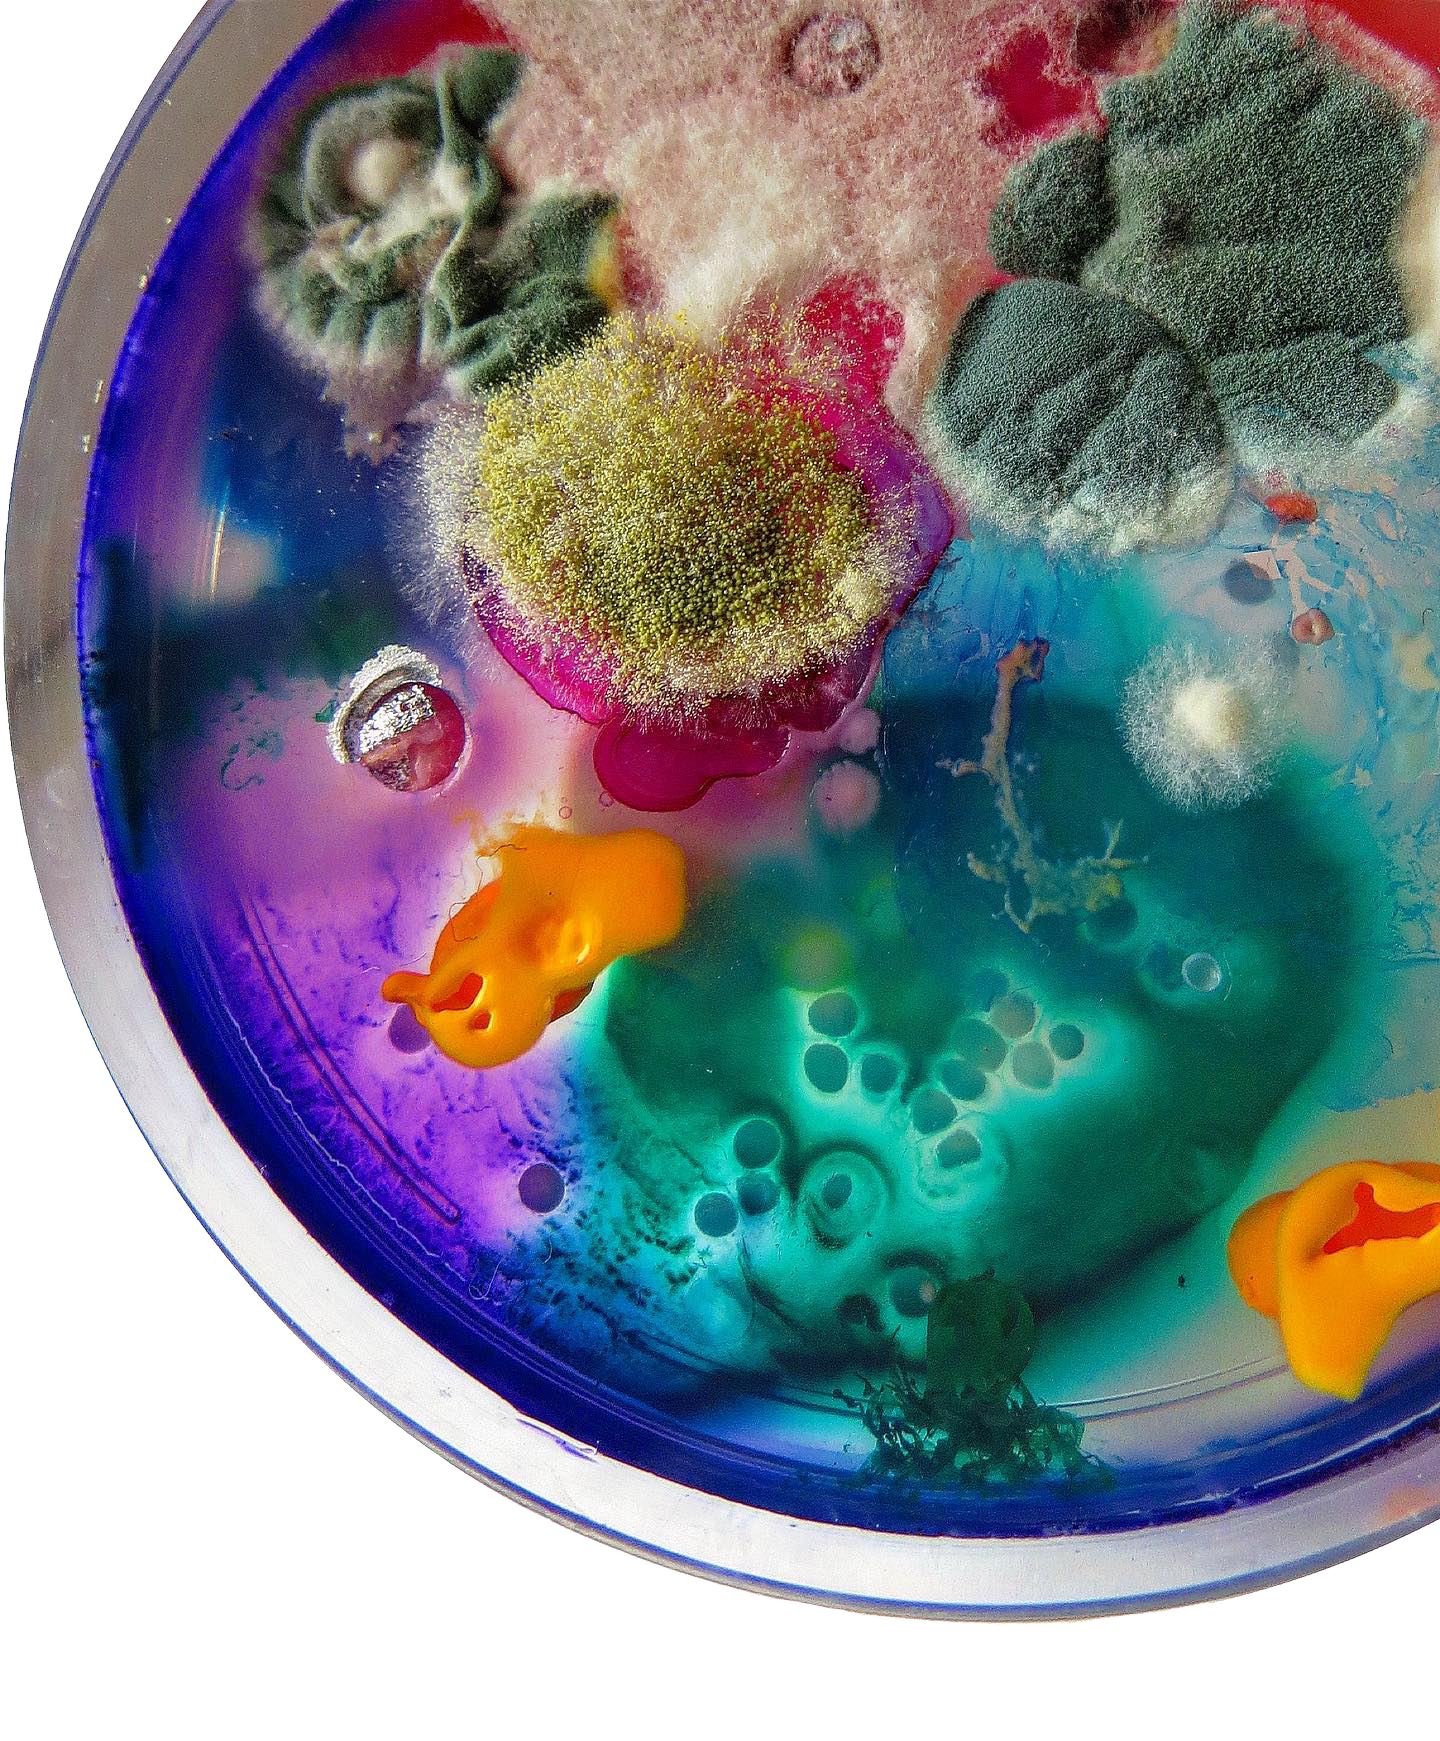

Blazing a trail
toward a regenerative future
Fungi VC backs invests in frontier fungal innovations shaping a world where nature and people prosper. We invest early in bold founders and scientists transforming fungi into scalable solutions, from bio-based materials and environmental remediation to climate and industrial breakthroughs. enabling a regenerative society — where nature and people prosper.
Early-stage | Global | Environmental & bio-based solutions
The Fungi Thesis:
Why Fungi, why now?
Fungi have shaped life on Earth for billions of years. Now, advances in science, biotechnology, and climate urgency are unlocking their power at scale.
As Scientific American notes, we are at the beginning of a fungi revolution, yet we’ve only begun to tap its potential to transform materials, food systems, chemicals, construction, waste, and climate solutions.
Fungi VC exists to back the pioneers turning fungal science into scalable, regenerative businesses, right when the world needs them most..
Pure
Focus
One of the few investment vehicles dedicated entirely fungal innovation
Deep Ecosystem Access
Embedded in the global fungi science and startup community

First-mover advantage
Early access to pioneering founders and frontier technologies
Regeneration First
Environmental impact is core to value creation, not a by-product
Investment Themes
Mycelium-based materials & consctuction
Alternative proteins & next-gen food systems
Bio-based chemicals & industrial processes
Global Ecosystem & Deal Flow
Fungi VC is deeply embedded to the global fungi innovation ecosystem.
Like a mycelial network, we unlock proprietary deal flow through The Future is Fungi Award, — a global launchpad for spotlighting and accelerating frontier fungal science and startups worldwide.
This platform gives Fungi VC early, privileged access to emerging teams, breakthrough technologies, and high-conviction investment opportunities.
Waste valorization & circular systems
Climate, soil, and ecosystem regeneration
Managing Partner, Susanne Gløersen
A pioneer in fungal innovation and regnerative investing, Susanne founded The Future is Fungi Award, a global launchpad for startups and science entrepreneurs turning fungal breakthroughs into real-world impact. She is an angel investor in early-stage fungal ventures and a recognized voice in sustainability and climate-focused finance.
WIth 15+ years of leadership in finance and sustainability, Susanne has held senior roles at SEB, Nordea, Formue and Carnegie, including Sustainability Lead at SEB Green Tech VC. She is a VC Lab alum and completed the Oxford Venture Finance Programme, bringing deep expertise in scaling frontier technologies globally.
She serves on the advisory boards of NoMy (Norwegian Mycelium), and Mycela, guiding the next generation of regenerative founders.
Shape the Future with Fungi
Partner with Fungi VC in turning frontier fungal technologies into the next wave of sustainable solutions that matter.